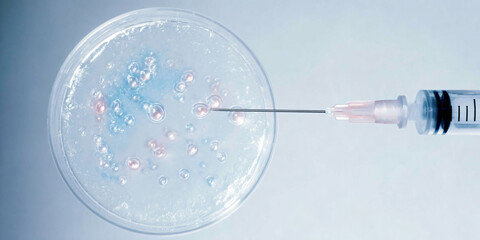
Cellular Microinjection in Petri Dish

- Home >
- Stock Photos >
- DNA Strand with Vaccine and Syringe on Dark Background
DNA Strand with Vaccine and Syringe on Dark Background Image

Conceptual representation featuring DNA strand alongside vaccine vial and syringe, symbolizing ongoing advancements in genetic research and biotechnology. Ideal for use in contexts highlighting innovative healthcare, medical breakthroughs, or vaccine developments.
downloads
Tags:
More
Credit Photo
If you would like to credit the Photo, here are some ways you can do so
Text Link
photo Link
<span class="text-link">
<span>
<a target="_blank" href=https://pikwizard.com/photo/dna-strand-with-vaccine-and-syringe-on-dark-background/b44e8bb2b43d00fe656976e00ac7d422/>PikWizard</a>
</span>
</span>
<span class="image-link">
<span
style="margin: 0 0 20px 0; display: inline-block; vertical-align: middle; width: 100%;"
>
<a
target="_blank"
href="https://pikwizard.com/photo/dna-strand-with-vaccine-and-syringe-on-dark-background/b44e8bb2b43d00fe656976e00ac7d422/"
style="text-decoration: none; font-size: 10px; margin: 0;"
>
<img src="https://pikwizard.com/pw/medium/b44e8bb2b43d00fe656976e00ac7d422.jpg" style="margin: 0; width: 100%;" alt="" />
<p style="font-size: 12px; margin: 0;">PikWizard</p>
</a>
</span>
</span>
Free (free of charge)
Free for personal and commercial use.
Author: Awesome Content
Similar Free Stock Images
Loading...